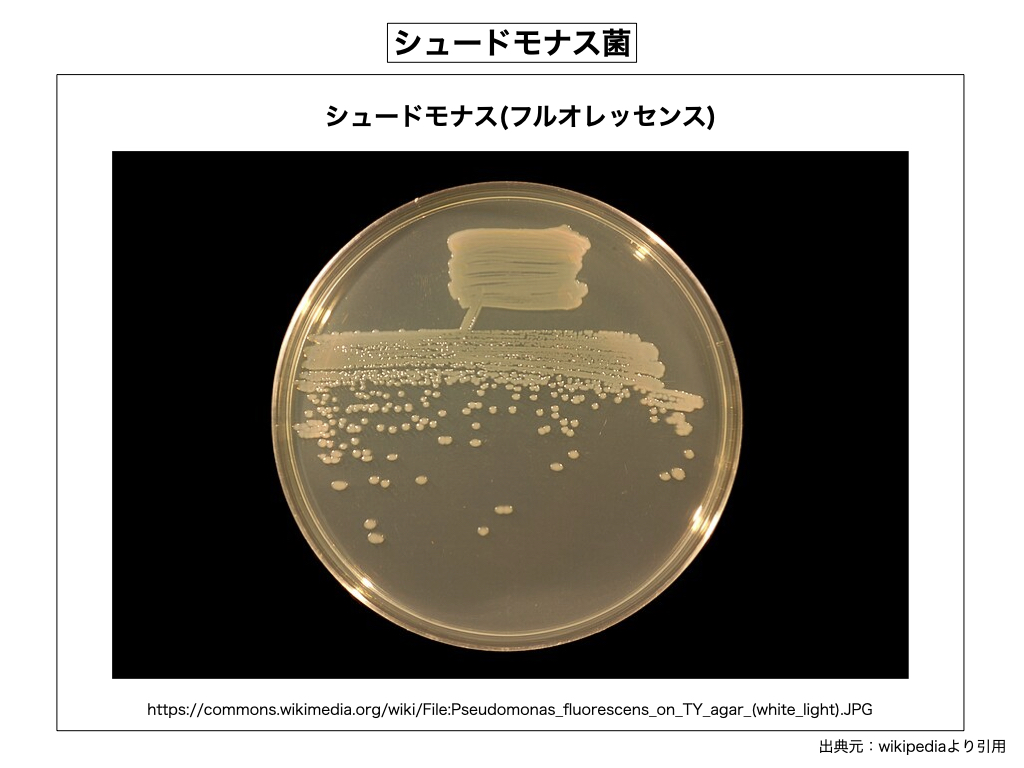

〈宇宙医学の実践治療法(その10)〉
G 「皮膚」の諸病(中編)
皮膚組織の上を「ヒール」が取り巻き、またそのヒールの上を「魂体」が取り巻いているのが、アストラル器官を含めた人体の基本的な構造である。皮膚病の中にはヒールや魂体などのアストラル器官の故障が原因して発症している病気も多く、普段は物体をいとも簡単に貫通してしまうアストラル組織であるが、なぜか物理的なダメージに弱く、意外と簡単に壊れてしまう傾向が強い。一般に人体のヒール組織や魂体組織を傷付けたり破壊できる物と言えば、神々攻撃の「光速ズザネ弾攻撃」や、マクロ宇宙の敵攻撃である「物質貫通弾攻撃」や、核爆弾や原子炉や太陽から繰り出される「放射線バースト」や、陽子線(重粒子線)などの「ピンポイント照射」や、交通事故や落下事故などによる「強い衝撃」や、煮湯を被るなどの「熱湯火傷」や、天罰系の「死の呪文」を打ち込まれた場合などである。アストラル器官がこうした物理刺激に弱い理由から、肉体のダメージがさほど無いにも関わらず、なぜか身体が見た目以上に重篤な状態に置かれているケースも多い。龍神島民族は聖地民族である理由から、マクロ宇宙からの敵攻撃や、他民族の神々からの攻撃がやたらと多いのが特徴である。また国家自体が原子力を扱っている関係上、RAD分子(放射性微粒子)吸収による「体内被曝率」や体液の「ラジカル濃度」が極端に高い特徴を有している。健全なアストラル器官を維持できている方が、日本人には一体どれ程居るのだろうか。
そこで今回は特別に、日本人1億2000万人の全員を対象に一斉調査を敢行し、人体のアストラル器官の破損の程度をチェックして見る事となった。その結果は驚くべきもので、修理が必要な魂体やヒールを抱えている人が実に約3000万人(4人に一人)にも上り、また今直ぐ修理並びに交換が必要とされる重篤な患者が150万人だった。150万人の多くが入院患者だった。また人体アストラルと言えば、頭部魂の「大脳12アンテナ」も含まれるが、3000万人の中で頭部魂にダメージを食らって大脳12アンテナが停止している方(認知症併発)が1800万人にも上った。人体の外側に存在するアストラル器官(魂体と皮膚ヒール)が破壊される一番の原因は、その七割方がマクロ宇宙から地球へ撃ち込まれる「物質貫通弾」と、地球神達が人体へ打ち込んで来る「光速ズザネ弾」だった。人体に撃ち込まれた場合、どちらも「バツン」と言う強い衝撃を全身で感じるもので、家に撃ち込まれた場合は「バッチン」とか「ビキッ」と言う天井や壁の「ラップ音」として聞こえて来るものである。一発の物質貫通弾やズザネ弾は魂体やヒールに穴を開けて、肉体組織の内部にまで侵入して来るか、もしくは体を打ち抜いて貫通して行く。当たり所が悪ければ、たった一発の被弾で命を落としてしまうケースもあるし、また被弾したその日から認知症や脳溢血を発症してしまうケースもある。
無論、日本人だけが特別な被害に遭っている訳では無く、総人口の1/4と言う被害比率はどの国でもほぼ一緒、国家が壊れてしまいそうな患者数の多さであるが、残念ながら現行のゲルマン医学ではアストラル器官を治療する事は出来ない。我々としてはこの現実を厳格に受け止めて、地球医学が1日も早く「物質医学」から脱却し宇宙医学の方へ軌道修正して頂きたいと願っている。現実問題として空の上から降って来る物は「雨粒」だけでは無いからである。今回の調査でもう一つショックだった事がある。福島原発の事故以来、RAD分子被害が徐々に落ち着いて来た現状であり、日本人の体内ラジカル濃度がかなり低下している筈だったが、残念ながら実際の数値は150%から250%と言う値を示しており、下がる所か反対に上がっていた事である。これは携帯も含めた液晶画面を有する電子機器の普及や、LED照明などの普及に原因があると考えられ、また薬やサプリメントやシャンプーやリンスと言った日常品の化学ラジカルの摂取も大きな原因の一つだと考えられる。体内ラジカル濃度が200%以上と言う数値は異常であって、癌が頻繁に発生し、糖尿病の悪化を何度も繰り返す危険な濃度なのである。宇宙医学ではこうしたラジカル対策を真っ先に講じている。
さて、魂体やヒールが破壊されると、場所によっては皮膚や身体にサイン(兆候)が出現して来る。それが一体何のサインであるのか、それを見極める事が重要であり、宇宙医学の多少の知識は学んでおかなければ、その病気の根本原因が何処に存在するのか、永久に分からない事になってしまう。今回は魂体第1ホルモンである「ヌクイリ・ホルモン)」と、魂体第2ホルモンである「ヌシビリ・ホルモン」と、魂体第3ホルモンである「ヌツギリ・ホルモン」と、また二種類の頭頂ヒール・ホルモンに関する宇宙医学の具体的な知識を述べようと思う。
① 魂体第1ホルモン(ヌクイリ腺)・・・左手を伸ばした指先の辺りに存在する魂体(オーラ球)壁のホルモン腺で、そのサイズはピンポン玉ぐらいである。ここから放出される常時性のホルモンは魂体の磁場環境を維持する役割であり、主に生命型(魂型=位相型)に基づく磁場環境を提供している。固有の細胞電磁場を囲う体細胞群は魂体の磁場環境の中で息づいて活動しており、異型の魂体侵入を一番忌み嫌う。例えばB型基盤の魂体はA型基盤の魂体の侵入に対して拒否反応を示す様に、他磁場に磁化される事を一番恐れているのである。それでも、この磁気ホルモンが機能している間は他磁気を跳ね返す力がある為に、多少の異型魂体との接触は短時間で有れば大きな問題とはならない。さて、問題はこのホルモン腺が物質貫通弾や物理衝撃を食らって損傷を被り、ホルモン分泌が低下してしまった場合である。損傷の比率で病気の現れ方が異なるが、1/4(25%)程度の低下で有れば誤魔化し運転が可能であり、またホルモン腺も多少は自力復活が見込めるが、1/3(33%)以上の減少では確実に病状となって現れて来る。ホルモンの減少率と病状の推移を述べると、軽い順番から、好酸球性副鼻腔炎(難病)、好酸球性中耳炎、好酸球性気管支炎、好酸球性肺炎、好酸球性食道炎、好酸球性胃腸炎(難病)、好酸球性筋膜炎(難病)、好酸球性多発血管炎性肉芽腫症(難病)などである。


魂体第1ホルモンの減少で特徴的な事は「好酸球の増大」である。白血球の仲間で一番磁性が強いのが好酸球であり、好酸球が磁化され難い血球であると言う特徴と、もう一つは身体のあちこちから放出される劇物の「ヒスタミン」を抑制できる能力がある為に、魂体環境の異常事態を察した皮膚ヒールが守備を固める行動を起こすのが一連の「好酸球増多症」の経緯である。早い話が、魂体の安定した磁場環境を失ったヒールが磁化防止作戦に打って出る話であるが、一体何から身を守っているのかと言えば、両親や兄妹や伴侶や同僚など、自分の身の回りに居るいつも接している異型魂体の持ち主達を敵対視しているのである。好酸球が増えすぎると命にも関係して来るが、それでも増え続ける事から「馬鹿」としか言い様が無い。しかし、ヌクイリ腺を修理し分泌量を正常な状態に戻してやれば、僅か2〜3週間足らずで通常の血液状態へと戻ってしまうからビックリである。猛烈な痒みに襲われる皮膚はまるで赤黒いオレンジの皮の様なガビガビ皮膚に見えるが、ホルモンを回復させれば、元の綺麗な皮膚へと戻って行くし、また自然に痒みも消えて行く。好酸球が吐き出すサイトカイン(ケモカイン)が痒みの原因だからである。地球医学では「好酸球」や「IgE抗体」と言えばアレルギー反応を想定するが、アレルギー反応を異型磁気に対する「拒否反応」だと理解すれば分かり易いかも知れない。
② 魂体第2ホルモン(ヌシビリ腺)・・・このホルモン腺は臍(へそ)から真っ直ぐ魂体壁の突き当たり付近に存在する物で、その大きさはピンポン玉サイズである。魂体第1ホルモンは磁場の環境ホルモンだったが、魂体第2ホルモンの方は磁場の活性ホルモンであって、個々の細胞の電磁場に作用して、細胞を活性に導く重要な常時性のホルモンである。このホルモン腺が物理的に衝撃を受けてホルモン分泌が完全に停止した場合は、体の全ての免疫力を失ってしまう理由から、あっと言う間に感染して、約一、二ヶ月間で死に至るのが一般的である。第1ホルモンは皮膚に異常が出現し好酸球が増えると言う特徴があるが、第2ホルモンの場合には明確な兆候が無く、ある日体の異変に気が付いたら、身体がいつの間にか細菌だらけになっていたと言う状況である。これは特徴と言えるかどうかは分からないが、魂体第2ホルモン腺が破壊されると、皮膚の細胞活性が一挙に失われて一斉に壊死を起こして行く。最初は血の気を失って皮膚は白く変じて行くが、免疫軍も抵抗力を失ってしまう事から、直ぐに常在菌に感染して重篤な感染症を引き起こす。「レンサ球菌」や「クロストリジウム菌」などに感染した場合は「壊死性筋膜炎」や「壊死性蜂窩織炎」を引き起こし、皮膚は熱を持って赤く変じて行く。そしてあっと言う間に皮膚が根こそぎ剥がれ落ちて死に至るのが通例である。これらの魂体ホルモン腺の異常はその多くが、物質貫通弾で魂体が射抜かれた結果起こるもので、こうした魂体の修理は宇宙医学の得意分野と言っても構わない。

③ 魂体第3ホルモン(ヌツギリ腺)・・・このホルモン腺(長さが15cm厚さ8cmぐらいの円筒形の筒)は右足の斜め後方の魂体癖に存在する器官であり、ここから魂体壁全体をガードする磁気ホルモンが放出されており、肉体には直接作用しない魂体維持専用のホルモンである。しかし、この部位が壊されてしまうと魂体の電磁線集合体の強度が薄れて、磁場の独立性を失い、他の魂体の侵入を簡単に許してしまう様になる。特に普段は地面や建物の床にめり込んだ状態の器官故に、いつの間にか打撃を受けて傷付いている場合が多い。修理が可能である事から、定期的な検診が必要である。また魂体は「物質貫通弾」を被弾しているケースが多く、また霊体のズザネ弾攻撃でも傷付くので、霊障が多い方は特に気を付ける必要がある。このホルモン腺が正常に機能していない場合は、その方が他の霊魂体の溜まり場になるケースが多い。また、このホルモンの減少が第1ホルモンや第2ホルモンの分泌量の減少と比例する事から、第3ホルモンが体とは無関係な存在である事は決して無い。宇宙医学では霊魂体の憑依を避ける為に「霊魂体未侵入バリア」を会員の魂体に被せてガードしている。無論、霊魂体の侵入は防げても、霊体の侵入(ズザネ管やタボ線の侵入)を食い止めるバリアはこの世には存在しない。

魂体の生命型とアレルギーの関係性を詳しく分析して見ると、「アレルギーとは何たるか」が良く見えて来るものだ。アトピー性皮膚炎が黄色ブドウ球菌だけの仕業であるとは当初は考え難かったが、この菌の外毒素である「エンテロトキシン」を分析して見て納得せざるを得なかった。黄色ブドウ球菌が産出する「エンテロトキシン」は耐熱性の「蛋白毒」であり、この蛋白質を分解できる酵素が人体には無い事から、アレルゲン(抗原)として磁性を有したまま体内に居残る為に、免疫軍が出動し毒素に「IgEマーカー」を付けて白血球(ロボット細胞)に処理させていた。問題はエンテロトキシン毒が種によって成分が異なり12種類も存在する事と、皮膚に潜伏している世代菌(毒素を定期的に放出している犯人)を免疫軍が発見できない為に、根絶が出来ないと言う事である。人体に異種蛋白が侵入すれば、当然「拒否反応(毒素対応)」が起こって免疫軍が出動する事になる。それでも侵入した異種蛋白を分解してその「磁性」を解体できれば、それは毒では無く栄養素となってしまう。蛋白質とは固有の磁性を有した「生き物」に他ならない。
小麦や大麦の胚乳蛋白にしても、大豆蛋白にしても、牛乳蛋白にしても、ピーナツにしても、卵白蛋白にしても、アレルゲンとなるのは必ず磁性を有した生きた蛋白質であり、それらを加熱処理して磁性を破壊してやれば、生の蛋白質では無い為に、激しいアレルギー反応は原則的には起きない筈である。しかし、魂体が一度食して「嫌悪感」を示せば、その情報が肥満細胞に伝えられて「アレルゲン・レセプター」なるものが形成されてしまう。そうなってしまうと、その食物を口で触れただけでも、あるいはそれを見ただけでも、アレルギー反応(1型反応)が起こって来る。従って、宇宙医学では肥満細胞に形成された「アレルゲン・レセプター」を切断し、アレルギー反応を強制的に抑制している。魂体とヒールと免疫軍は基本的に一体の物であって、連中は一枚岩で動いている。ところで、異種蛋白質の磁性を崩せば、それで安心と言う訳では無い。分解酵素が無ければ、それ以上分解できないし、また途上産物までしか分解できない物も存在する。これらは「不耐症」の原因物となり得る。これは一般的な話であるが、食べ物の好き嫌いは原則的に魂体が決めており、魂体が食べたい思う物は、たとえそれが毒物であっても毒にはならない。魂体が「嫌だなー」と感じた食材を嫌々ながら口にすると、腹痛や下痢症状を起こす場合がある。
人間であろうと、犬猫であろうと、鳥や金魚であろうと、魂体は自己の生命型に忠実であり、同型以外の生命型を基本的に受け付けない。しかし、それでは犬猫であっても生物社会に溶け込めないので普段は我慢をしている。生命型は宇宙の全生物に共通しており、生物同士はどうしても互いに「馬が合う(抵抗感が無い)」同型の生命体と仲が良くなってしまう。「我が家の猫は主人の私になかなか懐かない」と言った場合は、飼い主の人間がB型基盤なのに、ペットの猫がA型基盤で有れば、その猫は主人に抱かれる事を嫌がるし、また主人の魂体領域(膝の中)から外へ逃れようとする。A型の猫はB型の磁気に晒されるのが嫌なのである。一頭の牛の乳を絞って飲んだ所、普段は牛乳では下痢を起こさないのに、直ぐ様ピーピー状態を呈してしまったと言う場合がある。無殺菌の牛乳を飲んだ性だと思っていたら、実はその雌牛の生命型がA型基盤であれば、その牛乳蛋白もA型基盤であって、B型基盤の人間魂体が「嫌だなー、この牛乳」と感じたから下痢をもよおしたのである。魂体のこうした原始本能に付き合いたくは無いが、肉体の主人は魂体なので、それを心や理性で強行に封じても、体を悪くするだけの話である。
④ 頭頂ヒール腺(右) キケネイ腺・・・この常時性のホルモンは頭頂から内部の脳血管内に放出されるもので、 皮膚の均一性と皮膚機能の恒常性を保つ調節ホルモンであり、「皮膚細胞調整ホルモン」と呼ばれ る。血管内に入ったホルモン分子が外の皮膚ヒールと呼応して作業を行う。このホルモンに不足すると表皮(ケラチノサイト層)の角質層の角質化が異常に加速されて、厚くなった角質が増殖硬化して丘状扁平に隆起して来る所の、いわゆる胼胝(タコ)や鶏眼(うおのめ)が発生し易くなる。

⑤ 頭頂ヒール腺(左) ライネイ腺・・・この常時性のホルモンは内部の脳血管内に放出されるもので、 皮膚の再生を促す作用を持ち「皮膚細胞再生ホルモン」と呼ばれる。皮膚(表皮)の切り傷や火傷を治癒 するホルモンであり、このホルモンが不足すると傷口が綺麗に再生されない事から、表皮水疱症が発生して来る。感染性の水疱症(例えば天疱瘡)とは異なる水疱症はこのヒール・ホルモンの不足が関係しており、先天的にキケネイ腺やライネイ腺が奇形だったり、また生まれ付き不揃いだったり、全く無い方もいる。
⑥ 感染性水疱症・・・キケネイ腺やライネイ腺が健全な状態なのに、表皮や真皮に水疱(水ぶくれ)やびらんが発生して来る場合は、何かの病原体に感染しているか、もしくは何かの病原物質に対して皮膚が拒絶反応を起こしていると考えられる。以前、皮膚の難病の調査で「尋常性天疱瘡」や「落葉状天疱瘡」の原因が植物性のウイロイド(ヒノキ科ビャクシン属)による感染病である事を突き止めたが、今回はもっと大規模な調査を敢行し、徹底した調査を行なって見た。その結果、ビャクシン属の木(庭木)が有する四種類のウイロイドが人間の皮膚に感染する事実が分かった。一つは尋常性天疱瘡(玉イブキ)、一つは落葉状天疱瘡(金イブキ)、一つは紅斑性天疱瘡(銀イブキ)、一つはIgA天疱瘡(カイズカイブキ)だった。いずれもインフルエンザ・ウイルスの1/250と言う極小サイズのウイロイドであり、現在の電子顕微鏡でも測定する事自体が極めて難しい代物である。また、「天疱瘡」とも「類天疱瘡」とも病状が異なる表皮下水疱症の「疱疹状皮膚炎」と「線状IgA水疱性皮膚症」であるが、これらの追跡調査も行なって見た。その結果は皮膚に潜伏する世代菌が吐き出す蛋白毒が原因である事実が判明した。前者は「癌化緑膿菌」が放出する外毒素(エキソトキシンA)による水疱症であり、後者はクレブシエラ菌(ニューモニエ)の癌化世代菌が自己の周囲に作り出す「バイオフィルム」に対する拒否反応である。彼等は肺炎菌であるが、普段は防御が薄い皮膚に潜伏している。


次に70歳以上の高齢者に多い「水疱性類天疱瘡」であるが、これも癌化した「肺炎レンサ球菌」の世代菌が定期的に吐き出す外毒素による表皮下水疱症である。また「粘膜類天疱瘡」であるが、こちらは「緑膿菌」が産出するバイオフィルムに細胞外マトリックスの基底膜を構成する巨大蛋白(ラミニン)が磁化されて、異物と変じてしまった自己蛋白質に対して引き起こす拒否反応、それが水疱症となって現れている。また、天疱瘡や類天疱瘡以外の水疱症は「先天性表皮水疱症」も「後天性表皮水疱症」も「単純型表皮水疱症」も「ヘミデスモソーム型表皮水疱症」も「接合部型表皮水疱症」も「栄養障害型表皮水疱症」も、これらの病気には二種類の頭頂ヒール・ホルモンが関係しており、二つのホルモン分泌の程度差が病状の違いを醸し出しているに過ぎない。地球医学は不可解な現象に対して、遺伝子学者や免疫学者がシャシャリ出て来て、詭弁を労して無理やり正論化(正当化)している。推論も大概にしないと「詐欺研究」になってしまう。自然界はシンプルであり、難しく考えない事だろうか。宇宙医学に於いては、一連の水疱症治療は決して難しい治療では無い。四種類のウイロイド性天疱瘡は呼吸ブースによる自動排出で簡単に片付けられるが、世代菌の毒素や排出物が関係する四種類の水痘症は、潜伏菌も毒素も医療団による手取り排出をしなければならないし、それに壊れたヒール腺は新しく作り治す必要があって、治療にはそれなりのパースピレーション(発汗)が伴う。
⑦ 乾癬・・・地球医学では乾癬とは慢性の皮膚角化症状を始めとする全身炎症性の自己免疫疾患と定義されているが、「自己免疫疾患」と唄われる事自体が早い話が発症の原因が分からないと言う意味に他ならない。乾癬の類は「尋常性乾癬」と「関節症乾癬」と「膿疱性乾癬」と「滴状乾癬」と「掌蹠膿疱症」などに分かれるが、ここでは五種類の全ての原因を明らかにしようと思う。「尋常性乾癬」と「膿疱性乾癬」に付いてはブログの難病項目で原因を追究しており、前者はヒノキ科ビャクシン属の「ハイネズ」が有する「ウイロイド」が原因であり、また後者はウイロイドでは無くウイルスが原因だった。両生類のヤモリの宿生ウイルスが難病を引き起こしていた犯人だったが、このウイルスは珍しい反電荷(癌化)ウイルスであって、しかも発信器を備えていて免疫を操作できる恐ろしいウイルスだった。尋常性乾癬の患者の中で、約15%の発生比率であるが「乾癬性関節炎」を併発する方がいる。これはハイネズ・ウイロイドが関節内部へと侵入し、靭帯や腱や滑膜や骨膜などに定着する事によって炎症が発生するからである。次に子供に良く発症する「滴状乾癬」であるが、これもウイロイド疾患であるが、ハイネズ・ウイロイドとは別物であって、同じくヒノキ科ヒバ属の「チャボヒバ」のウイロイドが病原体である。ハイネズにしてもチャボヒバにしても、針葉樹系の庭木(コニファー・ガーデン木)として人間の生活と密着して存在している。


最後に「掌蹠膿疱症」であるが、この病気を乾癬の仲間に加えて良いものかどうか疑問を感じるが、この病気は基本的に細菌感染によって発症するもので、その原因菌とは人間の身体の何処にでも居る常在菌の「モラクセラ・カタラーリス」である。通常のモラクセラ菌と異なる所は彼等が反電荷を囲った癌化菌である事だ。癌化菌も癌化ウイルスも、それが反電荷故に検出が非常に難しく、一見無菌状態に見える為に「乾癬」の仲間に分類されたと考えられる。「掌蹠膿疱症」とは手の平や足裏に化膿性の炎症を起こす病状であるが、膿の内部にはモラクセラ菌がウヨウヨと蠢(うごめ)いている。癌化するとなぜ検出不能になるのか? その理由は「PCR増殖法」で細菌を培養し、それで核酸分析をしているからである。反電荷を帯びた細菌の塩基類は、正電荷のDNA鎖の上には物理的に配列しない事から、核酸の同定分析が出来ないのである。「細菌も居ないのに、なぜ化膿するのだろうか」医学的には不思議な話だが、だから「乾癬」の仲間に仕分けされている訳である。合理的なPCR同定法を使用すれば、正電荷ウイルスや正電荷細菌のDNAしか分析が出来ず、反電荷ウイルスや反電荷細胞を見逃してしまうのである。PCR同定法とはオリオンが仕掛けた「罠」に他ならなく、こんないい加減な装置は他に無い。

⑧ 膠原病・・・膠原病とは基本的に結合組織(コラーゲン組織)と血管の病気の疾患が首座を占める所の臓器も含めた全身病の事でであるが、一般的には「自己免疫疾患」と「リウマチ性疾患」と「結合組織疾患」の三種類が組み重なった様な原因不明の疾患群を意味している。典型的な症状としては、発熱、皮疹、倦怠感、関節痛、関節炎、筋肉痛、内臓病変、レイノー現象などがあげられるが、女性に患者が多いのが特徴である。現在、膠原病の範疇に属する病気は約20種類、いずれも原因不明であるが、宇宙医学に於いて既に原因を解明した病種も半分ほどある。病気には必ず原因が存在する。我々としては「膠原病」など言ういい加減な分類病名を用いないで頂きたいと思っている。下記は地球医学に於ける膠原病の一覧表であるが、宇宙医学で突き止めた病気の主原因をそれぞれ記載している。この病気はこれが原因であると、記憶を整理し易い様にコンパクトに説明しており、常識的に頭に留めておいて欲しいと思う。
1) 関節リウマチ(RA)・・・自己の免疫軍が手足の関節を襲い、これによる関節痛や関節の変形が生じる炎症性の自己免疫疾患病である。比較的早く関節炎が進む場合は「癌化シュードモナス菌」の発信器が原因する「サイトカイン関節炎」であり、何十年間と言う長い年月を掛けて慢性的に進行する場合は「霊魂体憑依」が原因する「磁化病」が根本原因である。ちなみに、悪性慢性関節リウマチは「霊障」が招く「業病」であり、磁化病は宇宙医学でも治す事は出来ない。
2) 全身性エリテマトーデス(SLE)・・・皮膚や臓器や神経に様々な病状を呈する原因不明の難病であり、患者の90%が女性と言う奇妙な特徴があって、また皮膚には赤い紅斑が現れると言う特徴を示す。この病気の原因は「ウイロイド」であり、生花で使用する「ウスイロジンチョウゲ」が放出するガスを吸って併発するウイロイド病である。ガス吸引が少ない場合は「皮膚エリテマトーデス(DLE)」を併発し、大量に吸い込んだ場合は全身性となる。

3) 強皮症・・・皮膚が硬化して行くタイプ(限局性強皮症)と、皮膚のみならず内臓が硬化して行くタイプ(全身性強皮症: SSc)に分かれるが、いずれも「ウイロイド病」であり、「ハクモクレン」が有するウイロイド・ガスを吸引した場合に発病する。この病気も女性に患者が多い(90%)のが特徴である。ウイロイド・ガスが皮膚から侵入した場合と、口から大量に吸い込んでしまった場合は重症度が異なる。

4) 皮膚筋炎(DM)と多発性筋炎(PM)・・・この病気は皮膚に大変特徴的な表情を出す病気であり、顔面皮膚には「ヘリオトロープ疹」、手指の関節の裏側には「ゴットロン丘疹」が出現する。基本的には横紋筋の筋膜に炎症が起きる病気である。この病気の主原因は「ウイルス」であり、鳥類の「鵜(う)」が有する宿性ウイルスであって、「癌化ウイルス」なのがその特徴である。早い話が、鵜が一度飲み込んだ魚を食して感染する病気である。

5) 結節性多発動脈炎(PAN)・・・比較的細い中型から小型の動脈血管が炎症を起こす病気であり、昔は結節性動脈周囲炎と呼ばれた病気である。この病気は昆虫の「ケラ・ウイルス」が主原因であり、ケラの血液で作られる宿生ウイルスに感染して発病する。

6) 混合性結合組織病(MCTD)・・・この病気も女性に多く、患者の97%が女性である。病状は全身性エリテマトーデスと多発性筋炎と全身性強皮症をミックスした様な病状を呈する。実はこの病気の根本原因も「ウイロイド」であり、花の「アヤメ」や「ハナショウブ」や「カキツバタ」などが茎に有する「ウイロイド・ガス」を吸引した場合に発症して来る。

7) シェーグレン症候群(SjS)・・・全身性の自己免疫疾患病の一つで患者の90%が女性と言う特徴的な病気である。この病気の主原因はカビの癌化古細菌種である「ニューモシスチス・イロベチイ」であり、この菌が有する発信器が免疫活動を抑制する原動力である。女性に多い理由はこの菌が植物に寄生しており、植物から感染するからである。

8) 顕微鏡的多発血管炎(MPA)・・・血管炎症候群の一つで、主に毛細血管や細動脈や細静脈の血管壁に炎症が起こり、出血したり血栓が形成されたりする病気。ANCA(抗好中球細胞質抗体)に関連する小血管炎であり、肉芽腫性病変が見られない血管炎である事が特徴である。この病気の主原因は「昆虫ウイルス」であり、甲虫類の「テントウムシ」の血液の中で生産される宿生ウイルスに感染して発症する。

9) 多発血管炎性肉芽腫症(GPA)・・・別名を「ウェゲナー肉芽腫症」とも呼ばれる血管の病気であり、主に中型から小型の全身の動脈が侵される重篤な病気である。血液検査に於いてはMPAやEGPAと同様に「c-ANCA(PR3-ANCA=抗好中球細胞質抗体)」の値が上昇するのが特徴である。この病気の主原因は哺乳類が平均的に体内に有する「マイコプラズマ」が原因であり、主に死んだ動物の遺体から感染する病気である。マイコプラズマが死体から遊離する前に焼却したいものだが、自然界ではそうは運ばない。

10) 好酸球性多発血管炎性肉芽腫症(EGPA)・・・この病気の別名は「アレルギー性肉芽腫性血管炎」もしくは「チャーグ・ストラウス症候群」とも呼ばれる。全身の動脈に壊死性血管炎を起こし、血管の内外へ肉芽腫を生じさせる重篤な病気であり、好酸球の浸潤が最大の特徴である。この病気の原因は「魂体第1ホルモン(ヌクイリ腺)」と言う環境ホルモンの分泌低下によって引き起こされている。身体のアストラル組織が破壊された場合に生じる病気であるが、最近は「物質貫通被弾」によるものが多いが、その昔は「墓荒らし」などに対する天罰系呪文の一つとして「ヌクイリ腺破壊呪文」が使用されて来た経緯がある。

11) 過敏性血管炎(皮膚血管炎: CSVV)・・・この病気は皮膚の小型もしくは中型の血管が侵されるもので、皮膚に紫斑、点状出血、網状皮斑、結節、潰瘍などの症状が現れる。この病気の主原因は「昆虫ウイルス」であって、昆虫のアブの血液で生産される「アブ・ウイルス」によって引き起こされている。

12) ベーチェット病・・・この病気は口腔粘膜のアフタ性潰瘍や、外陰部潰瘍や、皮膚症状や、眼症状など四つの主症状を首座とする慢性再発性の全身性炎症疾患である。この病気の主原因とは「鉄(Fe)イオン」の過多症である。まあ、鉄イオンをコントロールする事が出来ない病気と言えば正解である。下垂体の前葉からは15種類のホルモンが分泌されているが、その中の一つに「重元素凝集ホルモン(ヌイエニア)」が存在する。このホルモンの分泌が滞ると、血中の鉄イオンを貯蔵庫へ収納する事が出来なくなり、鉄イオン過多症を呈して来る。

13) コーガン症候群・・・この病気は血管の慢性炎症性疾患の一つで、主に「内耳障害」と「眼症状」を首座とする血管炎症候群の一つである。この病気は基本的にウイルス病であるが、人間の脳内に寄生するヘルペス系ウイルスによる疾病であり、HIV-10型の「豚ヘルペス・ウイルス(発信器有り)」によって引き起こされている。

14) RS3PE症候群・・・1985年にアメリカで提唱された「謎の関節炎」であり、正式な和名はまだ無い。宇宙医学では「癌化シュードモナス菌」の発信器弊害であり「サイトカイン関節炎」と称している。リウマチ因子と抗核抗体陰性であり、関節炎や滑膜炎の発症患部が両側性で対称性なのが特徴である。
15) 巨細胞性動脈炎(GCA)・・・この病気は全身の動脈(大型や中型血管)に巨細胞を伴う肉芽腫が形成される動脈炎であり、特に外頸動脈を高い頻度で障害する高齢者に多い疾患である。実はこの病気は海洋環境の陽化に伴う「サンゴの白化(サンゴ死)」と関係があり、「サンゴ・ウイロイド」を吸い込んだ者が発症する病気である。

16) 成人スティル病(ASD)・・・この病気は基本的に慢性関節炎を呈するが、リウマチ因子が陰性であって、毎日の定期的な発熱症状(間欠熱)と、それに伴う淡いピンク色の皮疹が特徴である。幼児の段階では無く、満16歳以上の年齢の者が発症した場合を成人スティル病と称している。この病気の根本原因はシュードモナス菌と同様な、癌化した土壌バクテリアの一種である「デイノコッカス球菌」の発信器による弊害である。

17) リウマチ性多発筋痛症(PMR)・・・北欧の高齢者に多い病状であり、その昔は「老人性リウマチ性痛風」と呼ばれていた。四肢の対称性疼痛や強張りを主徴とする疾患である。この病気の主原因は北方圏の海洋に生息するイソギンチャクが放つウイロイドであり、「イソギンチャク・ウイロイド」を吸い込んだ者が発症する病気である。

18) 線維筋痛症(FMS)・・・全身に激しい痛みが生じる慢性的な疼痛を主徴とする病気であり、その激しい痛みは「ガラスの破片が体中を流れる感じの痛み」と表現されている。実はこの病気も海洋性の生き物が放つ「ウイロイド・ガス」を吸引した結果、発症するもので、その生き物とは「ヒトデ」である。「ヒトデ・ウイロイド」は痛いと思って頂ければ良いと思う。

19) SAPHO症候群・・・この病気の和名は「掌蹠膿疱性骨関節炎」であり、原因菌は常在菌の「モラクセラ・カタラーリス」であり、その癌化菌である。SAPHOとは滑膜炎(S)、座瘡(A)、膿疱症(P)、骨化症(H)、骨炎(O)の頭文字を連ねたもので、掌蹠膿疱症が進んだ状態と解釈できる。

以上が膠原病と思しき病気の実態であるが、いずれも原因がそれぞれ異なる。宇宙医学では「ウイルス」と「ウイロイド」に関しては既に呼吸ブースへ防御データが入力されており、自動的に体外へ排出されるが、「細菌」や「真菌」に関しては医療団を派遣して菌本体や発信器や毒素を強制的に排出させない限り、病気は治らない事になる。また体内のホルモン分泌に関しても医療団に調節してもらわない限り、自然に良くなる事は無い。無論、治せないのは「磁化病(慢性関節リウマチ)」であり、取り敢えずの「誤魔化し治療(磁気の上塗り戦法)」で補っている。
